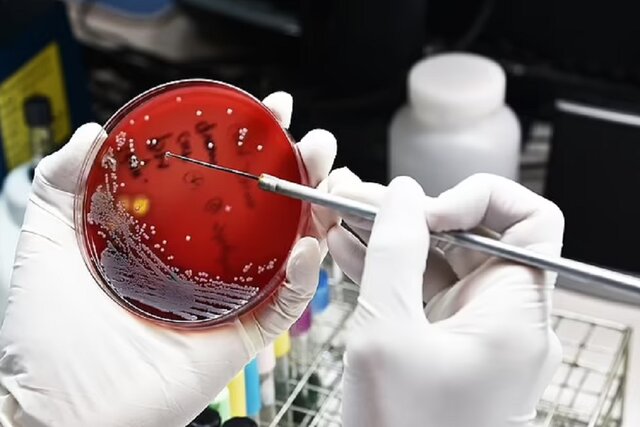
آلودگی هوا عامل افزایش مقاومت آنتیبیوتیکی است

پژوهشگران چینی در یک پژوهش جدید نشان دادهاند که آلودگی هوا ارتباط مستقیمی با افزایش مقاومت آنتیبیوتیکی دارد.
به نقل از دیلی میل،
یک پژوهش جدید هشدار داده که یکی از بزرگترین تهدیدها برای سلامت جهانی
ممکن است به دلیل بالا رفتن سطح آلودگی هوا در حال افزایش باشد.
پژوهشگران چینی در این پروژه، یک ارتباط جهانی را بین وجود آلایندهای
به نام «PM۲.۵» در هوا و ایمنی باکتریها در برابر داروهای آنتیبیوتیک
یافتهاند. اگرچه آنها مطمئن نیستند که چه چیزی عامل این ارتباط است اما
حدس میزنند که باکتریهای مقاوم به آنتیبیوتیک با PM۲.۵ موجود در هوا
منتقل میشوند. آلایندههای PM۲.۵، ذرات یا قطرات کوچکی با قطر کمتر از ۲.۵
میکرومتر هستند که با چشم غیرمسلح دیده نمیشوند.
مقاومت آنتیبیوتیکی به شرایطی گفته میشود که طی آن، باکتریها در
واکنش به داروهای ضد باکتری جدید و مواد شیمیایی که برای از بین بردن آنها
طراحی شدهاند، با داروها سازگار میشوند و تکامل مییابند و به
اَبَرمیکروبهای فوقالعاده قوی تبدیل میگردند. پژوهشگران هشدار دادهاند
که مقاومت آنتیبیوتیکی، یک معضل جهانی جدی است که سالانه باعث مرگ
میلیونها نفر در سراسر جهان میشود.
این پژوهش که در «دانشگاه ججیانگ»(Zhejiang University) انجام شده است،
برای اولین بار نشان میدهد که مرگهای زودرس ناشی از مقاومت آنتیبیوتیکی
تا حدودی ناشی از آلودگی PM۲.۵ هستند.
پژوهشگران نوشتند: این اولین تحلیلی است که ارتباط بین PM۲.۵ و مقاومت
آنتیبیوتیکی بالینی را در سطح جهانی توصیف میکند. ما نشان دادیم که
همبستگی بین PM۲.۵ و مقاومت آنتیبیوتیکی، در بیشتر باکتریهای مقاوم به
آنتیبیوتیک سراسر جهان ثابت مانده و این همبستگی به مرور زمان تقویت شده
است.
«مارک هولمز»(Mark Holmes) استاد ژنومیک میکروبی «دانشگاه کمبریج» که در
این پژوهش شرکت داشت، گفت: هیچ مدرکی دال بر وجود یک رابطه علتومعلولی
بین این دو عامل وجود ندارد.
به عبارت دیگر، گروه پژوهشی به طور قطع نمیدانند که آیا آلودگی هوا
باعث مقاومت آنتیبیوتیکی میشود یا خیر اما نمونههای DNA نشان میدهند
این احتمال وجود دارد. هلمز گفت: ما ژنهای مقاومت آنتیبیوتیکی را در DNA
توالییابیشده پیدا کردهایم که از نمونههای هوا به دست آمدهاند و ممکن
است نشانههایی از مکانیسم احتمالی را ارائه دهند.
این گروه پژوهشی، دادههای مربوط به استفاده از آنتیبیوتیک و مقاومت به
آن را از سال ۲۰۰۰ تا ۲۰۱۸ در ۱۱۶ کشور از جمله بریتانیا، آمریکا، چین،
هند و استرالیا مورد بررسی قرار دادند. آنها این نتایج را با دادههای
مربوط به آلاینده PM۲.۵ مقایسه کردند که از همان کشورها و همان دوره زمانی
به دست آمده بودند.
همبستگی قابل توجهی بین PM۲.۵ و مقاومت آنتیبیوتیکی در هشت گونه از ۹
گونه باکتری مقاوم به آنتیبیوتیک از جمله باکتری «اشریشیا کلی»(E. coli)
دیده شد که در سطح جهانی ثابت بود. نتایج نشان دادند که هر ۱۰ درصد افزایش
PM۲.۵، با افزایش ۱.۱ درصدی مقاومت آنتیبیوتیکی مرتبط است.
نکته قابل توجه این است که سطوح بالایی از مقاومت آنتیبیوتیکی در شمال
آفریقا، خاورمیانه و جنوب آسیا یافت شدند. این در حالی بود که اروپا و
آمریکای شمالی، سطوح پایینی از مقاومت آنتیبیوتیکی داشتند.
این گروه پژوهشی هشدار دادند که اگر هیچ سیاستی برای جلوگیری از آلودگی
هوا اعمال نشود، مقاومت آنتیبیوتیکی تا ۱۷ درصد افزایش مییابد و مرگومیر
سالانه ناشی از مقاومت آنتیبیوتیکی تا سال ۲۰۵۰ در سطح جهان، تا ۵۶.۴
درصد بالا میرود.
پژوهشگران در ادامه نوشتند: شمال آفریقا و غرب آسیا مناطقی هستند که
بیشترین آلودگی PM۲.۵ را دارند. سیاستهای کنترل PM۲.۵ در این مناطق ممکن
است به بروز تغییرات قابل توجهی در مقاومت آنتیبیوتیکی منجر شود.
این موضوع به خوبی شناخته شده که علل آلودگی هوا شامل سوزاندن سوختهای
فسیلی، فعالیتهای صنعتی و کشاورزی و انتشار گازهای گلخانهای از اگزوز
خودروها هستند.
در حال حاضر تصور میشود که استنشاق PM۲.۵ میتواند آسم، بیماریهای
ریوی و قلبی و حتی علائم افسردگی را به همراه داشته باشد اما این پژوهش
نشان میدهد استنشاق PM۲.۵، ما را با اَبَرمیکروبهایی نیز آلوده میکند که
میتوانند ما را بکشند.
با وجود ارائه شدن یافتههای این پژوهش، علت اصلی مقاومت آنتیبیوتیکی
همچنان استفاده بیش از اندازه آنتیبیوتیکها در نظر گرفته میشود. به همین
دلیل است که بسیاری از متخصصان سلامت اکنون در صورت امکان، از تجویز کردن
آنتیبیوتیک برای عفونتهای جزئی اجتناب میکنند.
هنگامی که ما از آنتیبیوتیکها استفاده میکنیم، برخی از باکتریها
میمیرند اما باکتریهای مقاوم میتوانند زنده بمانند و به لطف جهش در
ژنهایشان، در برابر داروها مقاومت کنند.
مقاومت آنتیبیوتیکی، بخشی از یک مشکل گستردهتر است که به عنوان
«مقاومت ضد میکروبی» شناخته میشود و علاوه بر باکتریها، سایر ارگانیسمها
مانند ویروسها و قارچها را نیز در بر میگیرد. اکنون یک صنعت علمی کامل،
به هدف قرار دادن مشکل جدی مقاومت ضد میکروبی و اَبَرمیکروبهای ناشی از
آن اختصاص داده شده است که داروها دیگر با آنها سازگار نیستند.
«سازمان جهانی بهداشت»(WHO) تخمین میزند که این اَبَرمیکروبها تا سال
۲۰۵۰، سالانه ۱۰ میلیون نفر را میکشند و بار ۱۰۰ تریلیون دلاری را بر
اقتصاد جهانی تحمیل میکنند. گفته میشود این موارد مرگومیر به دلیل
عفونتهایی رخ خواهند داد که زمانی بیضرر در نظر گرفته میشدند.
سازمان جهانی بهداشت، مقاومت ضد میکروبی را به عنوان یکی از ۱۰ تهدید
بزرگ جهانی علیه بشریت اعلام کرده است و یک متخصص نیز شدت تهدید مقاومت ضد
میکروبی را در حد تروریسم میداند.
دانشمندان سال گذشته اعلام کردند که حدود ۱.۳ میلیون نفر در سال ۲۰۱۹ به
دلیل مقاومت ضد میکروبی در سراسر جهان جان خود را از دست دادند.
این پژوهش، در مجله «Lancet Planetary Health» به چاپ رسید.
انتهای پیام
منبع خبر :
https://www.isna.ir/news/